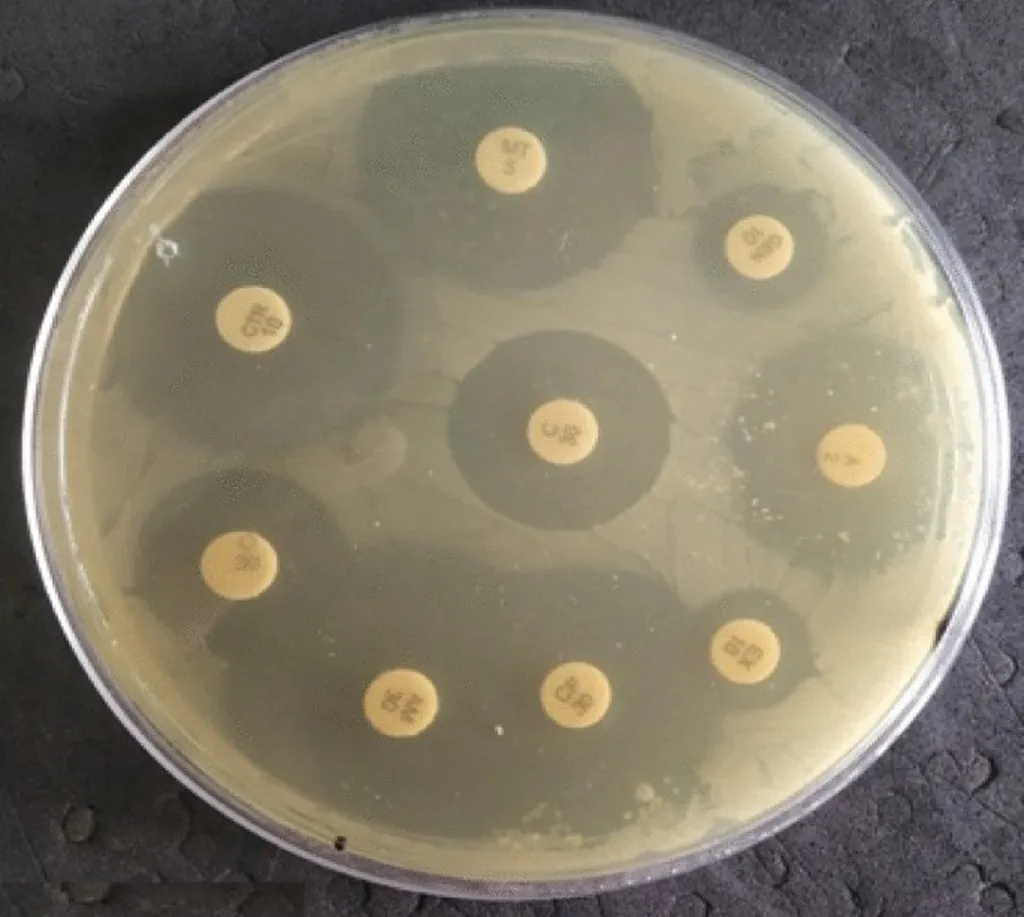

In the ever-evolving landscape of food safety, a recent study published in *Current Research in Food Science* has shed light on the genetic diversity and antimicrobial resistance of Clostridium perfringens, a bacterium that poses significant risks to both animals and humans. Led by Liting Wu from Nanjing Agricultural University and the Jiangsu Key Laboratory for Food Quality and Safety, the research delves into the complexities of this pathogen, offering critical insights that could reshape how we approach food safety and agricultural practices.
Clostridium perfringens is no stranger to the agricultural sector. Known for causing chronic diseases in animals and foodborne illnesses in humans, this bacterium’s complex toxins can lead to severe health issues, including diarrhea, necrotizing enteritis, and even death. The study, which analyzed various strains of C. perfringens derived from different geographical locations and animal sources, revealed alarming trends in antibiotic resistance and toxin production.
Antimicrobial resistance testing showed a notable prevalence of resistance among isolates, with 39.5% being resistant to clindamycin and 32.6% resistant to tetracycline. Even more concerning, 29.1% of the isolates were found to be resistant to at least two classes of commonly used antibiotics. “The identification of multi-drug resistance and toxin-encoding genes among the isolates underscores the concerning spread of antimicrobial resistance among C. perfringens affecting both animals and humans,” Wu emphasized.
The study also identified the most frequently occurring resistance genes, TetA(P) and tetB(P), associated with tetracycline resistance, present in 93.0% and 79.0% of the isolates, respectively. This finding highlights the urgent need for enhanced epidemic surveillance of C. perfringens in livestock settings to mitigate the risks of human transmission via environmental or food sources.
Multi-locus sequence typing (MLST) revealed that the 86 representative isolates belonged to 49 sequence types (STs), including 33 unique, previously uncharacterized STs. Furthermore, 30.23% of these STs were grouped into six clonal complexes (CCs). The diversity of CRISPR/Cas systems provided additional insights into the complex genetic correlations and evolutionary dynamics of pathogenic C. perfringens.
One of the most promising findings was the broad inhibitory effect of the phage SD72 against C. perfringens isolates, irrespective of ST types and antimicrobial resistance. “Bacteriophages present a promising avenue as bio-antimicrobial agents for controlling the transmission of C. perfringens from animal sources to humans,” Wu noted. This discovery could revolutionize the way we manage and control bacterial infections in agricultural settings, potentially reducing the reliance on antibiotics and mitigating the spread of resistance.
The commercial impacts of this research are profound. For the agriculture sector, understanding the genetic diversity and antimicrobial resistance patterns of C. perfringens can lead to more targeted and effective control measures. This could translate into healthier livestock, reduced economic losses due to disease outbreaks, and ultimately, safer food products for consumers.
The study also underscores the importance of continuous monitoring and research in the field of food safety. As Wu and her team have shown, the genetic landscape of pathogens like C. perfringens is complex and ever-changing. Staying ahead of these changes is crucial for developing effective strategies to combat foodborne illnesses and protect both animal and human health.
In the broader context, this research could shape future developments in the field of agritech. The use of bacteriophages as bio-antimicrobial agents is an innovative approach that could gain traction in the coming years. Additionally, the insights gained from this study could inform the development of new diagnostic tools and treatments, further enhancing our ability to manage and control bacterial infections in agricultural settings.
As we continue to navigate the complexities of food safety, studies like this one serve as a reminder of the critical role that research plays in shaping our understanding and practices. The findings from Wu’s team not only highlight the urgent need for enhanced surveillance and control measures but also open up new avenues for innovation and development in the field of agritech.